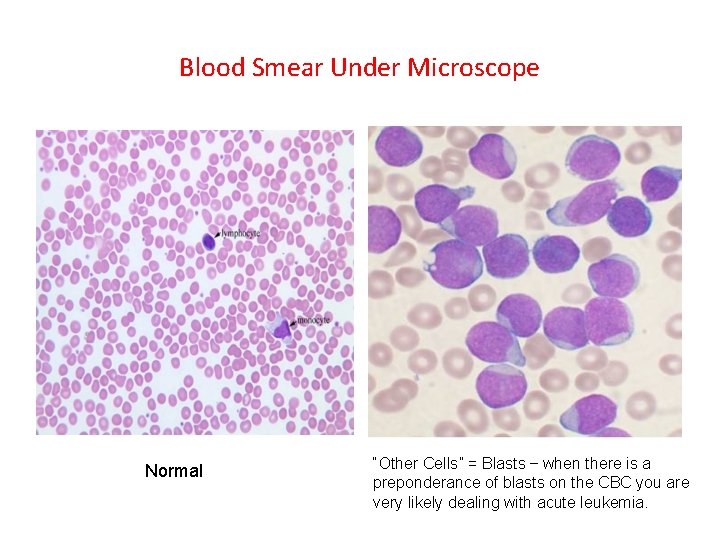
Blood Smear Under Microscope Normal “Other Cells” = Blasts – when there is a Blood Smear Under Microscope Normal “Other Cells” = Blasts – when there is a

Red Flags in the Diagnosis of Pediatric Cancer

- Slides: 44
Red Flags in the Diagnosis of Pediatric Cancer Geoff Cuvelier MD FRCPC Pediatric Oncologist Cancer. Care Manitoba Associate Professor, Dept of Pediatrics and Child Health. University of Manitoba Canadian Association of Physician Assistants Conference Winnipeg, MB. October 29, 2016
Disclosures • None • I will not be discussing any off-label indications for any drugs or medical devices. • I’m really sympathetic towards front-line health care workers and their role in diagnosing children with cancer. It can be difficult!
Objectives 1. To increase understanding among front-line healthcare workers (including physician assistants) that cancer in children does occur and to help you identify common and less-common cancer presentations. 1. To discuss how acute leukemia, lymphoma and brain tumors in children present to primary care health workers and what you can do to help make the diagnosis. 2. Provide you with the knowledge to initiate diagnostic and therapeutic interventions where there is an oncologic emergency.
How Often Will Primary Care Physicians See A Case of Childhood Cancer? • Infrequently: • Children (<15 yrs): • Adults: 14. 7 cases / 100, 000 children / year. 467. 7 cases / 100, 000 adults / year • Manitoba: About 60 new cases childhood cancer / year • In primary care …. Perhaps one child every 10 -15 years. • Problem: The parent expects you will know what to do and they are not happy when the diagnosis has been missed! (may have multiple health care visits)
Types of Childhood Cancer • * 1. Leukemia (ALL>AML>Chronic Leukemia) ………. 31. 0% • • • * 2. CNS tumors…………………… 18. 3% * 3. Lymphomas (Hodgkin’s, NHL) ………… 13. 8% 4. Neuroblastoma ……………………. . 6. 8% 5. Soft tissue sarcomas …………………. . 6. 2% 6. Wilms’ tumors ……………………. 5. 7% 7. Bone tumors ……………………. . 4. 7% 8. Retinoblastoma ……………………. 2. 5% 9. Germ cell tumors …………………. . 2. 4% 10. Liver tumors ……………………… 1. 3% 11. Other ………………………… 7. 4%
So…Isn’t Pediatric Oncology Sad? • Well sometimes … but not usually. In very “general” terms - Long-Term Survival: 1962 2016 • Acute Lymphoblastic Leukemia 4% 93% • Acute Myelogenous Leukemia 4% 60% (variable on genetics) • CNS tumors 35% 74% (variable on type) • Hodgkin’s Disease 50% 95% • NHL 6% 84% • Neuroblastoma 10% 69% (variable on stage) • Wilms’ tumor 50% 92% • Osteosarcoma 20% 63% • Ewing’s sarcoma 5% 65% (variable on stage) • Rhabdomyosarcoma 30% 64% (variable on stage)
Why Cancer Diagnosis Is Missed in Children • Not expecting the diagnosis “Cancer Doesn’t Happen in Children” • The parents are telling the story – quick assumptions • Mimics other conditions – “Mono” – Acute Leukemia, Lymphoma – “Asthma” – Acute Leukemia with Mediastinal Mass – “Tension Headache” / Migraine – Brain Tumor – “Trauma” – Osteogenic sarcoma
Case One • 3 year old girl brought to walk-in-clinic • Pale and tired for 1 week, fevers • Dx: “Viral Infection” • • 1 week later: Still tired, pale, fevers Limping, “Legs hurt” Dx: “Growing Pains”
Case One • 1 week later: • Getting worse • Now getting a red rash Petechiae – Sign of Thrombocytopenia
Case One • Physical Exam: • HR: 120 BP: 100/70 RR: 34 Temp: 38. 8 o. C • Unwell, Tired Appearing • Subconjunctival hemorrhages • Cervical Lymphadenopathy • Hyperdynamic precordium • Systolic flow murmur • Hepatosplenomegaly to just above umbilicus. ** What is the most important test?
Complete Blood Count • • • WBC: Hemoglobin: Platelets: Neutrophils: Lymphocytes: Other Cells: 35 x 109/L (N: 5 -15) 45 g/L (N: 120 -160) 2 x 109/L (N: 150 -450) 0. 2 x 109/L (N: 2. 5 -7. 0) 1. 0 x 109/L (N: 2. 0 -7. 0) 33. 5 x 109/L (N: none) • What is the most likely diagnosis? • Acute Leukemia
Blood Smear Under Microscope Normal “Other Cells” = Blasts – when there is a preponderance of blasts on the CBC you are very likely dealing with acute leukemia.
Acute Leukemia • Clonal malignancy of early blood cells that presents “acutely”: – Uncontrolled proliferation of immature malignant blood cells starting in bone marrow. – Destruction of normal hematopoiesis. – Systemic infiltration of organs (e. g. liver, spleen, lymph nodes, CNS, testes) § 2 Subtypes: – Acute Lymphoblastic Leukemia (ALL) – most common childhood cancer – Acute Myelogenous Leukemia (AML)
AML ALL
Acute Leukemia Presentation • Often over short time – days to weeks. • Constitutional symptoms: – Fevers – Malaise (often not going to school) – Anorexia / weight loss (sometimes) • Consequence of bone marrow being packed with blasts: – Limping – Bone Pain (legs, pelvis especially) – Hematologic (anemia / thrombocytopenia)
Acute Leukemia Presentation • Consequence of anemia: – Pallor – Tired / Headaches – Tachycardia / Tachypnea • Consequence of thrombocytopenia: – Petechiae / Purpura – Subconjunctival Hemorrhages • Consequence of organ infiltration: – Hepatosplenomegaly – Lymphadenopathy – Mediastinal mass – Testiculomegaly
Classification of Acute Leukemias by Cell of Origin For perspective only. . Don’t need to memorize these. Acute leukemias have been classified according to the predominant cell type. • ALL (still used) – pre-B cell (“precursor” B) – T-cell ALL • AML (older “FAB” – used still by convention but replaced by WHO classification) – M 0 – Undifferentiated AML – M 1 – AML without maturation – M 2 – AML with maturation – M 3 – “APL” Acute promyelocytic leukemia – M 4 – Acute myelomonocytic leukemia – M 5 – Acute monoblastic leukemia – M 6 – Acute erythroid leukemia – M 7 – Acute megakaryoblastic leukemia
Classification of Leukemia By Prognosis and Genetics • Classification systems are constantly changing – but in general increasing knowledge of molecular genetics and how this impacts prognosis is identifying different subclassifications. • Aiding to guide therapy – Very High Risk – Intensified therapies, stem cell transplant. Standard Risk – De-escalating traditional therapy. • ALL: – Standard Risk Low (double trisomies of chromosomes 4, 10) – Standard Risk Average – Standard Risk High (MLL gene translocation but rapid response to chemotherapy) – High Risk (MLL gene translocation but slow response to chemotherapy) – Very High Risk (e. g. genetic translocations with known high risk features such as t 9: 22 “Philadelphia” chromosome, <44 chromosomes in the blasts “hypodiploid”)
Case Two - Variation on the Leukemia Theme – Leukemia as an Oncologic Emergency • 14 year old boy presents with one week fevers, bone pain, headaches, tired and pale. Now trouble breathing. • O/E: Subconjunctival hemorrhages, multiple petechiae, lymphadenopathy, hepatosplenomegaly and facial plethora and fullness. • CBC: WBC: 252 x 109/L 98% Blasts (=Hyperleukocytosis) Hg: 75 g/L Plts: 2 x 109/L • Hyperleukocytosis – WBC >100 x 109/L. Blood becomes viscous and sludges. Increases the risk of: – cerebrovascular accident (ischemic and hemorrhagic). – pulmonary “sludging” and hypoxemia. – tumor lysis syndrome.
To Remind You – A Normal Chest X-Ray
Mediastinal Mass and SVC Syndrome with Hyperleukocytosis = Emergency • Mediastinal Mass: – Compromised airway – Anesthesia concerns • SVC Obstruction – Facial, Neck, and Arm Edema – Poor venous return from CNS – potential for stroke and cerebral edema. Adolescent with hyperleukocytosis and anterior mediastinal mass likely T-cell ALL.
The Anterior Mediastinal Mass • Wide differential diagnosis – some malignant some not. • “Terrible T’s”: – T-cell ALL – T-lymphoblastic lymphoma (cousin disorder to T-ALL) – Thymoma (or normal thymus in infant) – Thyroid Cancer – Teratoma (germ cell tumor) – Tuberculosis • Hodgkin’s Lymphoma
Normal Thymus of Infancy Wavy Sign Looks like a mediastinal mass – don’t be confused. Most infants <1 years old you will see this and it is normal. Involutes between 1 -3 years. Only 2% will still be visible on CXR by 4 years.
Case 2 – Adolescent with Hyperleukocytosis, Blasts, Large Mediastinal Mass, SVC syndrome • What is the responsibility of the physician assistant working in the ER or primary care clinic? Recognize this is an oncologic emergency Get the child out of your ER and to the tertiary children’s hospital. Call the pediatric oncologist on call. Start two peripheral intravenous lines. Do extended bloodwork – lytes, urea, creatinine, Ca, PO 4, Mg, LDH, uric acid. • Start IV fluids WITHOUT ADDED POTASSIUM at 2 -4 x maintenance fluid (assuming kidney function OK). • Do not start corticosteroids! (in some urgent situation may need to – but speak to pediatric oncologist first). • • •
Case Three – CNS Tumors • 4 year old, bit more cranky and irritable over last few weeks. Decreased play. • Complaining of headaches more often past week. • Mom has migraine history and thought it was this. Doctor agrees. • Dx: Migraines. Tylenol, rest, fluids. • Comes back – vomiting, walking abnormally (ataxia). • Sees the physician assistant who came to this talk and remembered…….
The Headache RED FLAGS • A headache is a brain tumor until proven otherwise when: – – – Child 7 or less years. Particularly bad in the early morning. Awakening at night from headache. Progressively getting worse over time. Associated with increased ICP or other neurologic symptoms and signs – vomiting, ataxia, nystagmus, deteriorating developmental milestones or school performance. – In an infant (<1 year) the head circumference is getting larger due to non-closure of the fontanelles and sutures.
Why Pediatric Brain Tumors are Missed • Not listening to the patient / parent – history, history • Not remembering the headache red flags. • Not doing a head circumference on an infant with open fontanelles and appreciating it is getting bigger too fast. • Not appreciating declining school performance or behavioral disturbance with headaches could be a brain tumor. • You need a CT scan of the head to rule in/out a brain tumor.
CT Scan of Head This is a Normal CT Scan showing normal ventricle size and basal cisterns.
This is Not Normal - Hydrocephalus Something is blocking the flow of CSF
Normal Flow of CSF Produces Hydrocephalus Here = Increased Intracranial Pressure Brain Tumor Blocking Here (Posterior Fossa)
Brain Tumors in Children • Classification – In part by location, cell of origin, and aggressiveness but in general profoundly confusing nomenclature and classification. • Some aren’t really even cancer (e. g. low grade gliomas) – Cause symptoms by compression – Removed by surgery only and are “cured” or at least no longer a problem for many years. • Others are highly aggressive malignancies with very poor survival (e. g. gliobastoma multiforme).
Posterior Fossa Tumor • 2 year old. Vomiting. Irritable. Walking “funny” (ataxia). Not hitting mouth with spoon / fork. Hydrocephalus on CT scan. Dx: Medulloblastoma. Mets to CSF. Surgery, Intensive chemotherapy, stem cell transplant, radiation therapy. High-risk disease. Survival ≈ 50%.
Posterior Fossa Tumor • 12 year old • Early morning headaches, awakening at night with headaches. • Low grade glioma • Surgery – complete removal = cure • Excellent outcome
Posterior Fossa Tumor • 5 -year old. 1 week history of going crosseyed, double vision, trouble swallowing food. • Note cranial nerve symptoms. • Dx: Diffuse Intrinsic Pontine Glioma • Not curable (will try radiation and chemo) • 6 -12 month survival
Brain Tumors Can Mimic Other Things • 8 year-old. Disruptive in class for last 2 -years. Dx ADHD. Trials of behavior management and Ritalin. • Getting worse. Declining school performance. Slowed speech. Very disinhibited. • MRI – Diffusely infiltrating CNS germinoma
Brain Tumors are Often First Seen by the Neurosurgeon • Medical Emergencies - rare (Increased ICP with herniation): – Altered Level of Consciousness – Fixed and Dilated Pupil – Eye “Down and Out” due to CNIII palsy – Abnormal posturing – Paralysis due to spinal cord lesion • Medical Urgencies – more common (some suggest – Headache and vomiting – Papilledema – Ataxia – Visual changes (loss of vision) – Nystagmus ICP):
Case Four – Hodgkin Lymphoma • • • 14 -year old boy. Increasing “swelling” of neck. 3 Large matted palpable masses (lymphadenopathy) in R anterior triangle and a supraclavicular node. Fevers, tired, night-sweats, 20 pound weight loss in last 4 weeks Confused with infectious mononucleosis (EBV). Normal CBC and Differential. LDH: 1400 (N: 150 -350) Mediastinal Mass
Clinical Pearl • Small (1 x 1 cm) lymphadenopathy in anterior/posterior cervical triangle or occipital area is common in children and often (but not always) related to infection…. BUT • A supraclavicular node is cancer until proven otherwise. Node Clavicle
Lymphoma • “Cancer of the lymphatic system” – Lymph nodes – Tonsils and adenoids (Waldeyer’s Ring) – Spleen • About 14% of childhood malignancies Lymph nodes are all over – know where they are
Lymphoma • 2 “broad” types: – Hodgkin lymphoma (HL) – Non-Hodgkin lymphoma (NHL) • Although named “lymphoma” the cancer is very different in children than adults: – Children: 50% HL 50% NHL – Adults: 10% HL 90% NHL • Adult NHL – most tend to be indolent, “slow growing”, nonaggressive. • Child NHL – very aggressive, widely spread to non-lymphatic tissues such as bone marrow and CNS.
How is Lymphoma Different Than Leukemia? • Leukemia – clone arises from a immature blood cell (e. g. lymphoblast) in the bone marrow and “spreads out” systemically to the lymph nodes, spleen, liver, etc… • Lymphoma – clone arises from a mature blood cells (e. g. Tlymphocyte) in lymphatic tissue and metastasizes to other lymphatic tissue, bone marrow, and other tissues.
Clinical Presentation of Lymphoma • • Lymphadenopathy – often painless Splenomegaly Hepatomegaly “B-symptoms” – weight loss, fevers, night sweats. Itching Pain in lymph nodes after alcohol consumption! Anemia Rapidly expanding abdominal mass = Burkitt’s lymphoma (a type of NHL)
Questions?